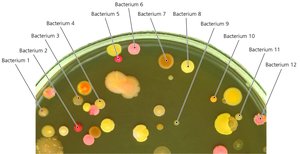
Bacterial colonies on agar plate
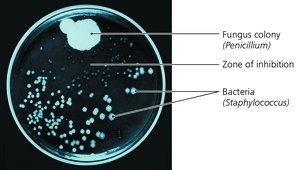
Penicillin inhibiting bacterial growth in a Petri dish

Back
BackChapter 1: A Brief History of Microbiology – Foundations and Key Discoveries
Study Guide - Smart Notes

Introduction to Microbiology
Microbiology is the study of organisms too small to be seen with the naked eye, including bacteria, archaea, fungi, protozoa, algae, viruses, and some multicellular parasites. This field has profoundly impacted medicine, industry, and our understanding of life itself.

The Early Years of Microbiology
Antoni van Leeuwenhoek and the Discovery of Microorganisms
Antoni van Leeuwenhoek is often called the "Father of Microbiology" for his pioneering work in developing simple microscopes and observing the microbial world. He was the first to describe "animalcules"—now known as microorganisms—by examining water, dental scrapings, and other substances.
Microscope Innovation: Leeuwenhoek crafted new microscopes for each specimen, allowing him to visualize bacteria, protozoa, algae, and fungi.
Impact: His observations laid the foundation for the field of microbiology.


The Microbial World
By the late 19th century, the organisms Leeuwenhoek observed were collectively termed microorganisms. These include a diverse array of life forms, many of which are essential to ecological and human health.

Classification of Microbes
Carolus Linnaeus developed a taxonomic system for naming and grouping organisms. Microorganisms are classified into six major categories:
Bacteria
Archaea
Fungi
Protozoa
Algae
Small multicellular animals
Bacteria and Archaea
Unicellular, lack nuclei (prokaryotic)
Smaller than eukaryotes
Reproduce asexually
Bacterial cell walls contain peptidoglycan; archaeal cell walls do not
Found in diverse environments, including extreme conditions (archaea)

Fungi
Eukaryotic (have a membrane-bound nucleus)
Obtain food from other organisms
Possess cell walls
Types:
Molds: Multicellular, filamentous, reproduce by sexual and asexual spores
Yeasts: Unicellular, reproduce asexually by budding, some produce sexual spores

Protozoa
Single-celled eukaryotes
Similar to animals in nutrient needs and cellular structure
Live freely in water or as parasites in hosts
Reproduce asexually (mostly) and sexually
Motility structures:
Pseudopods: Cell extensions for movement
Cilia: Short, numerous protrusions for propulsion
Flagella: Long, whip-like extensions

Algae
Unicellular or multicellular
Photosynthetic
Simple reproductive structures
Categorized by pigmentation and cell wall composition

Other Microorganisms
Parasites: Multicellular organisms, often with complex life cycles, some cause disease
Viruses: Acellular, require host cells to reproduce, cause many diseases


The Golden Age of Microbiology
Major Questions Addressed
Scientists in the 19th century sought answers to four foundational questions:
Is spontaneous generation of microbial life possible?
What causes fermentation?
What causes disease?
How can we prevent infection and disease?
Spontaneous Generation Debate
Aristotle: Proposed that living things could arise from nonliving matter (spontaneous generation).
Redi’s Experiments: Showed that maggots do not develop in meat isolated from flies, challenging spontaneous generation.

Needham’s Experiments: Supported spontaneous generation for microbes using boiled infusions.
Spallanzani’s Experiments: Contradicted Needham, showing that sealed and sufficiently heated infusions did not develop microbes.
Pasteur’s Experiments: Used swan-necked flasks to demonstrate that microbes come from the air, not spontaneous generation.


The Scientific Method
The debate over spontaneous generation contributed to the development of the scientific method, a systematic approach to scientific inquiry:
Observation
Question
Hypothesis
Experimentation
Analysis and Conclusion

Fermentation and Industrial Microbiology
Pasteur: Demonstrated that fermentation is caused by living organisms, not just air.
Pasteurization: Heating liquids to kill most bacteria, preventing spoilage.
Industrial Microbiology: Use of microbes to manufacture products (e.g., foods, beverages, pharmaceuticals).
Buchner: Showed that enzymes, not whole cells, can drive fermentation, founding biochemistry.

The Germ Theory of Disease
Pasteur: Proposed that specific diseases are caused by specific germs (pathogens).
Koch: Identified causative agents of diseases, developed laboratory techniques, and established Koch’s postulates for linking microbes to diseases.

Koch’s Postulates:
Suspected agent must be found in every case of the disease and absent from healthy hosts.
Agent must be isolated and grown outside the host.
When introduced to a healthy host, the agent must cause the disease.
Same agent must be found in the diseased experimental host.
Laboratory Innovations: Simple staining, photomicrography, Petri dishes, and steam sterilization.
Gram Staining
Gram’s stain is a differential staining technique that distinguishes between Gram-positive and Gram-negative bacteria, aiding in identification and classification.

Prevention of Infection and Disease
Semmelweis: Advocated handwashing to prevent puerperal fever.
Lister: Developed antiseptic surgical techniques.
Nightingale: Improved nursing and hospital sanitation.
Snow: Pioneered infection control and epidemiology.
Jenner: Developed the first vaccine (smallpox), founding immunology.
Ehrlich: Searched for "magic bullets"—chemicals that selectively kill pathogens (chemotherapy).

The Modern Age of Microbiology
Biochemistry and Metabolism
Modern microbiology investigates the chemical reactions of life, including metabolism, enzyme function, and the biochemical basis of disease and therapy.
Applications: Herbicide/pesticide design, disease diagnosis, metabolic disease treatment, drug design
Genetics and Molecular Biology
Microbial Genetics: Study of gene structure, function, and regulation in microbes
Molecular Biology: Explains cell function at the molecular level; gene sequencing reveals evolutionary relationships
Recombinant DNA Technology: Manipulation of genes for practical applications (e.g., producing human proteins in bacteria)
Gene Therapy: Inserting or repairing genes in humans to treat disease
Environmental and Applied Microbiology
Bioremediation: Use of microbes to detoxify polluted environments
Recycling: Microbes recycle carbon, nitrogen, sulfur, and other elements
Defending Against Disease
Serology: Study of blood serum and immune responses
Immunology: Study of the body’s defenses against pathogens
Chemotherapy: Use of chemicals to treat infectious diseases (e.g., penicillin, sulfa drugs)
Conclusion
Microbiology has evolved from simple observations of "animalcules" to a sophisticated science that underpins modern medicine, genetics, biotechnology, and environmental science. The field continues to grow as new questions and technologies emerge.
